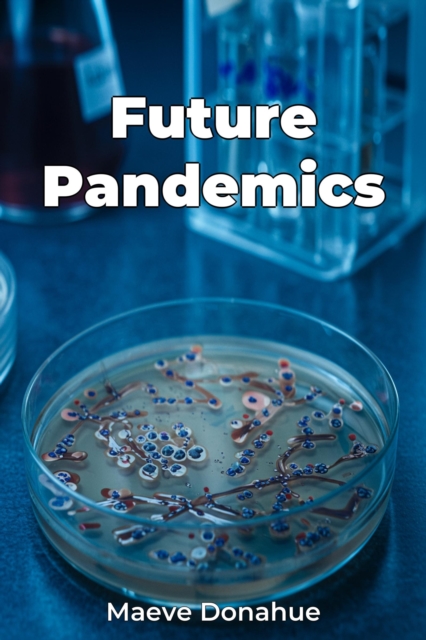
Future Pandemics

Future Pandemics
Future Pandemics addresses the crucial question of global readiness for future health crises, highlighting vulnerabilities exposed by COVID-19. It argues for a proactive, multifaceted approach encompassing scientific innovation, international collaboration, and robust public health infrastructure.
The book emphasizes the necessity of enhanced disease surveillance, noting how delays in detecting eme...
Future Pandemics addresses the crucial question of global readiness for future health crises, highlighting vulnerabilities exposed by COVID-19. It argues for a proactive, multifaceted approach encompassing scientific innovation, international collaboration, and robust public health infrastructure.
The book emphasizes the necessity of enhanced disease surveillance, noting how delays in detecting eme...
